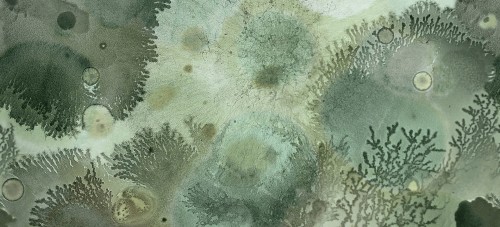
Tapeta pod prysznic w koralowce Wall&Deco WET_MU2102 Mufarina WET SYSTEM 2021

Wall&Deco WET SYSTEM 2021
 ! OKAZJA ! 282 cm x 297 cm Fototapeta łazienkowa Wall&Deco WET_WH2101 Where the Land Goes WET SYSTEM 2021
! OKAZJA ! 282 cm x 297 cm Fototapeta łazienkowa Wall&Deco WET_WH2101 Where the Land Goes WET SYSTEM 2021
 Tapeta egzotyczna Wall&Deco WET_KS2101 Kiss the Sky WET SYSTEM 2021
Tapeta egzotyczna Wall&Deco WET_KS2101 Kiss the Sky WET SYSTEM 2021
 Tapeta egzotyczna Wall&Deco WET_KS2102 Kiss the Sky WET SYSTEM 2021
Tapeta egzotyczna Wall&Deco WET_KS2102 Kiss the Sky WET SYSTEM 2021
 Tapeta w japońskim stylu Wall&Deco WET_RJ2101 Rhapsody in Japan WET SYSTEM 2021
Tapeta w japońskim stylu Wall&Deco WET_RJ2101 Rhapsody in Japan WET SYSTEM 2021
 Tapeta w japońskim stylu Wall&Deco WET_RJ2102 Rhapsody in Japan WET SYSTEM 2021
Tapeta w japońskim stylu Wall&Deco WET_RJ2102 Rhapsody in Japan WET SYSTEM 2021
 Tapeta w koralowce Wall&Deco WET_MU2101 Mufarina WET SYSTEM 2021
Tapeta w koralowce Wall&Deco WET_MU2101 Mufarina WET SYSTEM 2021
Tapeta w koralowce Wall&Deco WET_MU2102 Mufarina WET SYSTEM 2021
Tapeta w koralowce Wall&Deco WET_MU2102 Mufarina WET SYSTEM 2021
 Tapeta w liście Wall&Deco WET_WD2101 Wind Dance WET SYSTEM 2021
Tapeta w liście Wall&Deco WET_WD2101 Wind Dance WET SYSTEM 2021
 Tapeta w liście Wall&Deco WET_WD2102 Wind Dance WET SYSTEM 2021
Tapeta w liście Wall&Deco WET_WD2102 Wind Dance WET SYSTEM 2021
 Tapeta Wall&Deco WET_PB2101 Parlerie du Boudoir WET SYSTEM 2021
Tapeta Wall&Deco WET_PB2101 Parlerie du Boudoir WET SYSTEM 2021
 Tapeta Wall&Deco WET_PB2102 Parlerie du Boudoir WET SYSTEM 2021
Tapeta Wall&Deco WET_PB2102 Parlerie du Boudoir WET SYSTEM 2021
 Tapeta Wall&Deco WET_WH2101 Where the Land Goes WET SYSTEM 2021
Tapeta Wall&Deco WET_WH2101 Where the Land Goes WET SYSTEM 2021
 Tapeta Wall&Deco WET_WH2102 Where the Land Goes WET SYSTEM 2021
Tapeta Wall&Deco WET_WH2102 Where the Land Goes WET SYSTEM 2021
Wall&Deco WET System 2021 – tapety łazienkowe
Najnowsza kolekcja tapet łazienkowych od włoskiej marki Wall&Deco, to zbiór nietuzinkowych wzorów, które sprawią, że pomszczenia nabiorą głębi oraz charakteru. Spotkać tu można niebanalne motywy, które wyróżniają się unikatowym wzornictwem. Imitacja betonu, wzory w japońskim stylu, rośliny, zwierzęta, chmury czy geometria – to wszytko ukazane jest w nowoczesny sposób. Tapety w systemie WET są wodoodporne, dodatkowo odznaczają się bardzo dobra odpornością na uszkodzenia mechaniczne, oraz szkodliwe działanie detergentów. Tapety nie żółkną ani nie blakną, dzięki temu będą służyć przez lata. Takie tapety można zamontować pod prysznicem oraz w okolicy wanny. Bardzo dobrze odnajdą się w małych łazienkach, gdzie panuje bardzo wysoka wilgoć, a także w pokojach łazienkowych na centralnej ścianie. Okładziny ścienne w systemie WET można wykorzystać także w takich miejscach jak kuchnia czy w przestrzeni publicznej np. w salonach SPA, klubach fitness czy na basenie bądź w siłowni.
Tapety łazienkowe drukowane są na wymiar i dostarczane w brytach o szerokości 94 cm. System WET składa się z podkładu, kleju, tapety oraz impregnatu – całość dostarczana jest razem z tapetą. Zapytania o wycenę i wizualizację tapety łazienkowej, prosimy kierować przez formularz „zapytaj o produkt” lub droga mailową [email protected] .












































